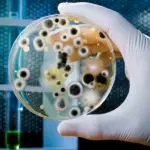

Leaving Mold to the Professionals
The last thing anyone wants to hear is that your home has been infested with mold. Not only is it costly and difficult to remove, mold is dangerous and can be hazardous. It is extremely important to remember that when dealing with mold, it is best to leave the remediation to a qualified, trained professional […]

3 Truths About Mold Damage & Your Health
In the 1980’s and part of the 1990’s, it was believed that people could potentially get sick from what the World Health Organization termed “Sick Building Syndrome.” Researchers at the time drew a direct correlation between poor indoor air quality in a water-damaged building to people getting sick. Today, we know more than that. The […]

Water Damage: 101
When your Fleetwood, PA home or business suffers from a flood or a water leak there is bound to be water damage. Water damage can range from a small spot of water in an isolated location to an overwhelming flood that damages your entire home or business. The type of water damage restoration services needed […]
